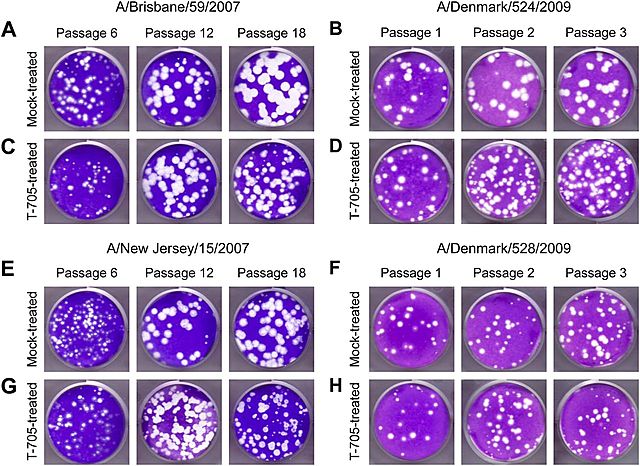
Caracterización in vivo e in vitro de H1N1
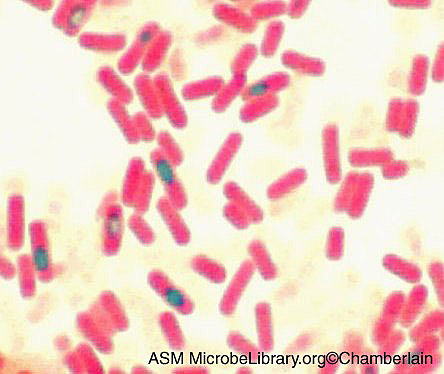
Esporas de Bacillus subtilis
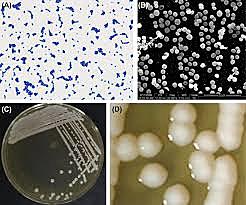
superbacteria resistente a todos los antibióticos conocidos Staphylococcus epidermidis

-
-
Se descubre que posee 2 cromosomas circulartes
-
-
-
-
Enfermedad de Creutzfeldt-Jakob (ECJ) es un tipo de encefalopatía espongiforme y se producen por la acción de una proteína prión cuya forma se altera.
-
Por Hopwood y col.
-
Virus del género Influenzavirus A de la familia Orthomyxoviridae . Son virus ARN segmentadosclasificados en A, (aves) B y C (Humanos).
Virus subtipo H5N1 -
Microorganismo que produce la enfermedad de los legionarios.
-
-
Adoptado como modelo de Lab. para estudiar esporulación (Difer. Celular) Usado como el equivalente Gram positivo de Escherichia coli, un bacilo Gram negativo
-
Primer lote en producción cotra dicho virus.
-
Por investigadores japoneses en solo 11 minutos
-
Test bacteriano para detectar mutágenos y carcinógenos de Bruce Ames . Rápido y económico
-
microcefalia anunciado por el Ministerio de Salud de México
-
la Organización Mundial de la Salud anunció que Ghana, Kenia y Malawi comenzarán a poner a prueba la primera vacuna
-
científicos en Australia advirtieron que una superbacteria resistente a todos los antibióticos conocidos que pueden causar infecciones "graves" o incluso la muerte se está extendiendo sin ser detectada a través de las salas de hospitales de todo el mundo. La bacteria, conocida como Staphylococcus epidermidis, está relacionada con el MRSA más conocido y más mortal.
-
Pérez (2013). Línea del Tiempo Microbiología. [online] Es.slideshare.net. Available at: https://es.slideshare.net/Yommanzana/lnea-del-tiempo-microbiologa [Accessed 25 Aug. 2019].
Timelines.ws. (2019). Timeline Microbiology. [online] Available at: https://timelines.ws/subjects/Microbiology.HTML [Accessed 25 Aug. 2019]. -
Timetoast. (n.d.). Sucesos Importantes de la Microbiología timeline.. [online] Available at: https://www.timetoast.com/timelines/sucesos-importantes-de-la-microbiologia [Accessed 25 Aug. 2019].
Looking for a timeline maker?
Create timelines for projects, roadmaps, history, lessons, legal cases, and stories with Timetoast. Timetoast is a timeline maker for work, school, research, and stories.